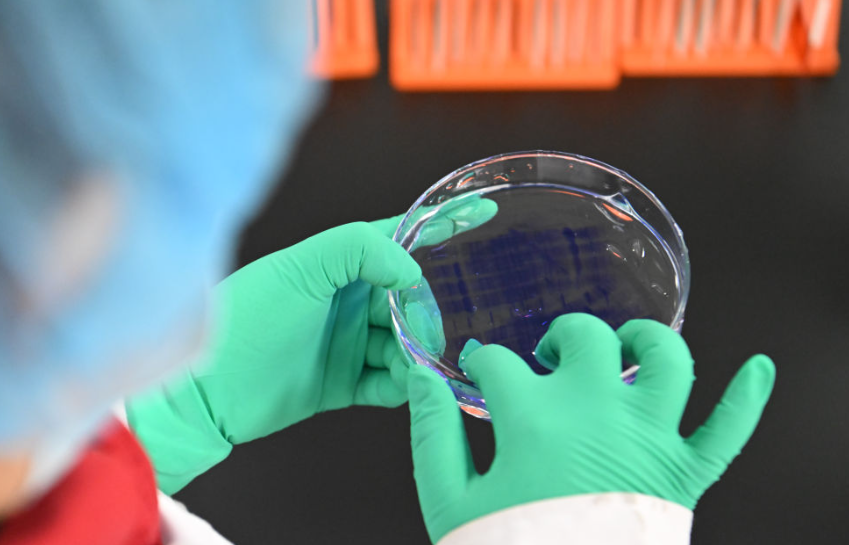
image.png image.png

国家统计局19日发布数据显示,2025年中国国内生产总值(GDP)1401879亿元,首次跃上140万亿元新台阶,按不变价格计算,比上年增长5.0%。

国家统计局局长康义表示,这一年,我国发展历程很不平凡,取得的成绩令人鼓舞,经济顶压前行、向新向优发展,主要预期目标圆满实现,“十四五”胜利收官,第二个百年奋斗目标新征程实现良好开局。“对于过去一年的经济表现,我想用‘稳、进、新、韧’这四个字来作简要概括。”康义说。

“稳”的格局得到巩固
2025年,国内生产总值首次跃上140万亿元新台阶,比上年增长5.0%;城镇调查失业率平均值是5.2%,就业保持总体稳定;货物贸易再创新高,外汇储备余额超过3.3万亿美元。


康义表示,2025年的中国经济,“稳”是突出的特点。对于我国这样超大体量的经济体而言,在各种风险挑战交织的背景下,能够实现这样的稳定发展很不容易。

复旦大学管理学院科创中心首席经济学家邵宇在采访中表示,“在一个比较大的基数基础上,再做5%的增长,所带来的整个经济的提升是非常明显的。”

“进”的步伐更加有力
康义在发布会上表示,这一年,我们始终坚定不移走高质量发展道路,加快推进新旧动能转换,推动改革开放走深走实,经济呈现向优向好的发展势头。


2025年,规模以上高技术制造业增加值占规模以上工业增加值比重升到17.1%,最终消费支出对经济增长贡献率超过五成。我国货物进出口总额比上年增长3.8%。民生保障有力有效,居民人均可支配收入实际增长5.0%,与经济增长同步。


内蒙古大学经济管理学院副教授王乾宇表示,最亮眼的信号来自于高技术制造业和装备制造业的持续领跑,其增速远高于整体工业,这表明以科技创新为主导的产业升级已成为主引擎。
邵宇说,“因为有了国补的方案,大宗商品的消费也有所提升,电子元器件,包括娱乐用品设施、家用电器、音视频的器材的消费增长还是非常高的。”


“新”的动能培育壮大
康义表示,2025年我国经济展现出“向新而行”的鲜明特征。2025年,研发经费投入强度达2.8%,比上年提高0.11个百分点,首次超过OECD国家平均水平。

世界知识产权组织数据显示,我国创新指数排名首次进入全球前十。从基础研究的新探索到关键技术的新突破,从科技创新与产业创新的深度融合到惠民成果的广泛落地,我国在人工智能、量子科技、脑机接口等前沿领域捷报频传,一批重大科研成果竞相涌现,新质生产力不断发展壮大。

广西大学经济学院经济学系主任郭南芸在采访中表示,新兴产业的出现是技术和需求双重驱动所带来的。“一方面是重大前沿基础研究的突破,形成具有市场需求的产品或服务。另一方面是需求拉动。随着人民群众对美好生活的追求,大家对智慧生活、数字体验、医疗健康、绿色消费、智能交互、智能交通等新需求不断涌现,为新兴产业带来发展机遇。”她说。


数据显示,2025年,规模以上数字产品制造业增加值比上年增长9.3%,服务器、工业机器人产量高速增长;绿电、绿能、绿色经济蓬勃发展,新能源汽车国内新车销量占比超过50%。
王乾宇认为,2025年的经济数据清晰展现了中国经济“向新向优”的深刻转型。“新质生产力作为核心驱动力,正从供给与需求两侧,重塑着中国经济的增长逻辑与未来图景。”他说。

“韧”的特性愈发凸显
康义在发布会上表示,这一年,世界经贸秩序遭受重创,国内新旧动能转换存在阵痛,在这样的情况下,我国经济仍然实现了“量的跨越”与“质的提升”,充分展现了中国经济在不稳定不确定环境下应变破局的能力和抗压耐压的韧性。


放眼全球,我国经济增速在主要经济体中名列前茅,是全球经济增长最稳定、最可靠的动力源,对世界经济增长的贡献率预计达到30%左右。稳外贸多样化格局加速形成,目前我国已成为150多个国家和地区的主要贸易伙伴,高技术、高附加值产品成为出口增长主力,外贸展现强大韧性。2025年高技术产品出口额比上年增长13.2%。
广西社会科学院东南亚研究所副所长张磊表示,数据背后,是中国外贸展现出韧性增长、结构优化与动能转换的鲜明特征。2025年我国外贸韧性凸显,结构升级驱动高质量发展,“新三样”与高新技术产品引领出口升级,市场多元化对冲风险。
王乾宇认为,宏观数据的“稳”与微观结构的“优”,证明了中国经济的韧性所在和希望所系。

2025年我国经济顶压前行、向新向优发展,主要的预期目标圆满实现,展现了强大韧性和活力,为今年经济发展奠定了良好的基础。

康义表示,看中国经济,要全面、辩证、长远地看,既要看当前之形,更要看长远之势;既看季度变化,更看全年走势;既看总量规模,更看发展质量。从2026年全年看,我国经济长期向好的支撑条件和基本趋势没有改变,经济高质量发展大势没有改变,有基础有条件保持经济稳定向好运行。



来源:新华社
编辑:文建美
 时刻新闻
时刻新闻